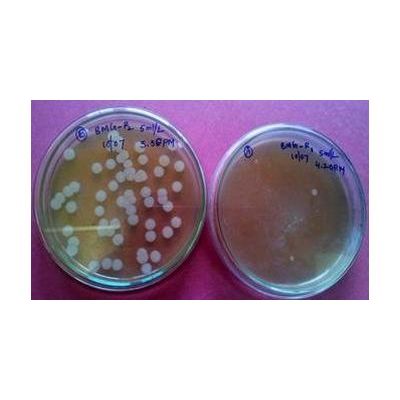

Terawet Green Technologies, Inc. (TGT)
- Home
- Companies
- Terawet Green Technologies, Inc. (TGT)
- Products
- Slivacide - Biocides
Slivacide - Biocides
Silv-Clean is specially developed to inhibit the growth of pathogens on any surface including harvested crops. Silv-Clean does not contain VOCs or harmful or ozone depleting chemicals. Silv-Clean is specially developed to eliminate offensive hospital odors on contact without masking them with fragrances.� It will effectively cleanse the air of offensive odors and complement existing ventilation systems. Jay Amarillas VP of Marketing/Partner Terawet Green Technologies Inc Terawetgreen@gmail.com 858-699-0604 www.terawet.comMost popular related searches
swimming pool water
nanoparticle
drinking water
drinking water safety
organic waste material
anti-bacteria agent
swimming pool
in vitro
toxicity study
water purification
A Bio-Safe, Eco-friendly, Green Technology
- For Use as a Disinfectant in Hospitals, on Harvested Crops and Bio Waste Materials
- Formulation Type: Powder / liquid
- Active ingredients (A.L.): Silver Ions embedded in a matrix of near nano amino acid as a suspension
Useful As:
- Antiseptic
- Astringent
- Biocide
- Cleanser
- Detergent
- Disinfectant
- Sterilizer
- UV Absorbent
- To inhibit growth of pathogens.
- To remove bad oders.
Only regular usage provides optimum results.
Recommended Usage:
- Harvested crops treatment: 2-3 ml per liter and liberally sprayed on the harvested plants
- Floor Mopping: 1-2 ml/ sq m
- Laundry: 1.5-2.5 ml/ Kg Linen
- Hand Wash: 1 ml/ wash
- Hazardous waste pretreatment: 20-25 ml diluted in 1 L water and liberally sprayed.
- Silver’s mode of action is presumed to be dependent on Ag+ ions, which strongly inhibit bacterial growth through suppression of respiratory enzymes and electron transport components and through interference with DNA functions.
- The active material in Silv-Clean is silver in nano-ionic form and in 1-10 nm size and is a completely stable carrier in form of suspension. Its stability has been tested in accelerated and long terms studies.
- Pure silver has the highest electrical and thermal conductivity of all metals and has the lowest contact resistance (Nordberg and Gerhardsson 1988) .
- Silver is long known as an antibacterial agent. Its nano-particles can kill all kinds of bacteria in very low concentration (about 5 ppm). It is also an antiviral and can fight against various kinds of viruses. It also acts as a photo catalyst.
- In the presence of air oxygen, it can produce free radicals, and these free radicals can affect the micro organisms and kill them.
- Silver can affect the di-sulfidic bands, between protein complexes. Thus the 3-d form of protein changes and it cannot perform as an enzyme. In case this happens in bacteria cell wall, the selective permeability of cell wall changes, therefore, bacteria swallows and will be destroyed. If this process occurs in energy cycle enzymes, then, the production of ATP stops and the lack of energy will kill microorganisms.
- On viruses, the glycoprotein knobs of viral envelop, that are virus antigenic receptors and has a di-sulfic band. This band could be attacked by silver nano particles & destroy the virus & prevents its attachment with host cell.
- With this mechanism of actions, silver nano particles can be used instead of all antibacterial agents and in preventive form; it can be even used as a vaccine.
- In "Biosynthesis of silver nanoparticles from Staphylococcus aureus and itsantimicrobial activity against MRSA and MRSE" (Anima Nanda MSc, PhD and M. Saravanan MSc, MPhil) it was found that not only was nano-silver effective in prohibiting the growth of 5 of the six bacteria strains tested, it was also found to be most effective against MRSA and MRSE, two well known "super bugs" resistant to antibiotics.
Tuesday, October 18, 2005 - FreeMarketNews.com
- In a groundbreaking study, the Journal of Nanotechnology has published a study that found silver nano particles kills HIV-1 and is likely to kill virtually any other virus.
- The study, which was conducted by the University of Texas and Mexico University, is the first medical study to ever explore the benefits of silver nano particles, according to Physorg.
- After incubating the HIV-1 virus at 37 C, the silver particles killed 100% of the virus within 3 hours for all three methods. While further research is needed, researchers are very optimistic that nanological silver may be the silver bullet to kill viruses.
Modern Colloidal Silver applications
- Numerous ingested toxicity studies have been completed on nano-silver products.
- Some of the studies are outlined below.
- Independent LD-50 tests on animals at levels equivalent to approximately 200 times the normal internal use adult dosage were found to be non-toxic to the animals.
- A 28-day bird flu study completed by a U.S. NIH virology lab also included a toxicity study in which the animals were fed levels of the nano-silver at 10-200 times the normal dosage daily.
- The ASAP nano-silver products were found to be non-toxic to the animals in the long term study.
- A separate medical college study tested the ingestion of nano-silver product in animals at levels of 0.5 ml, 1.0 ml, and 1.5 ml daily for 28 days, and again found the product completely non-toxic to the animals.
- An Indian (WHO approved) lab tested the ASAP nano-silver products for toxicity in a mouse-model study at levels of 50, 500, 5,000 mg/kg.
- The product was again found to be completely non-toxic to the animals at all levels tested in the Indian study.
- A peer-reviewed preliminary HIV Human study found that the oral ingestion of 2 ounces daily for four months of the 10 ppm ASAP nano-silver product, had no negative effect on the seven human patients.
- A U.S. Congressional Testimony outlines the use of the ASAP nano-silver product at between 0.5-1.0 ounce daily use at 10 ppm, for human use of the product against malaria and other human ailments (120+ cases).
- In all cases, no negative effects were reported from any of the four hospitals and clinics that tested the product, by either external or internal use (mostly internal use).
- Silver has been used for generations in goblets, silverware, and other food areas because of the belief that it inhibits diseases. In more recent times, the former Soviet Union used silver to sterilize recycled water on their space shuttles.
- Many international airlines use silver water filters to ensure safe drinking water for passengers.
- The Swiss have approved use of these filters in homes and offices. Some US city municipalities use silver in treatment of sewage and is sometimes used to purify swimming pool water to avoid the stinging of the eyes that chlorine causes. CS also purifies drinking water.
- Silver has become the latest agent in the fight against airborne toxins, as well other industrial poisons, in the Japanese work place.
- Dr.Henry Crooks (Use of Colloids in Health-Disease) found that silver in the colloidal state is highly germicidal, quite harmless to humans and absolutely non-toxic.
- Dr. Becker`s experiments conclude that silver works on the full spectrum of pathogens without any side effects or damage to any part of the body.
- Due to its antimicrobial properties, silver has also been incorporated in filters to purify drinking water and clean swimming pool water (Agency for Toxic Substances and Disease Registry [ATSDR] 1990, cited in World Health Organization [WHO] 2002).
Formulation type: Liquid suspension
- Active ingredients (A.I.): Silver Ions embedded in a matrix of near Nano Amino acid as a suspension.
- Common name: Silver (Ag) Colloidal Silver
- CAS#: 9015-51-4
- Contents: 50 – 100 ppm 400 nm size particle
Pure Silver characteristics:
- Molecular symbol: Ag
- Molecular weight: 107.87
- Boiling point: 2162 °C for pure silver
- Melting point: 961.78 °C for pure Silver
- Heat of Decomposition: Currently not available
- Reid Vapor Pressure: Currently not available
- Bulk Density: 10490 kg/m³ as pure silver
Solubility in water and organic solvents
Silver is insoluble. In this product it is in colloidal form and the particles are nano sized particles
Pure Silver Classification
- Silver is a Block D, Group 11, Period 5 element.
- The number of electrons in each of Silver`s shells is 2, 8, 18, 18, 1; its electronic configuration is [Kr]4d10 5s1.
- In its elemental form silver`s CAS number is 7440-22-4.
- The silver atom has a radius of 144.5.pm and it`s Van der Waals radius is 144.pm
- CAS No: 7440-22-4
- EINECS Number: 231-131-3
- RTECS Number: VW3500000
ORAL LD50:
- LD50 is 2854 mg/Kg of animal body weight
- The silver level is well below 180 micrograms / person / day permitted by W.H.O.
- Hence it is safe for human as well as aquatic and terrestrial animal life.
- Genetic toxicity in vitro- In vitro tests did not show any mutagenic effects
Storage and shelf life:
- Store in a dry location away from heat and out of direct sunlight in containers fitted with a safety valve or vent. Storage temperature: <104°F (40°C).
- Store in an area away from acids, bases, metals, metal salts, reducing agents, organic materials or flammable substances.
- Do not store near or expose to direct heat sources (ie: steam pipes, radiant heaters, hot hair vents or welding sparks)
- Rotate inventories - first in, first out.
- Materials to be avoided: Alkaline substances and antibiotics
